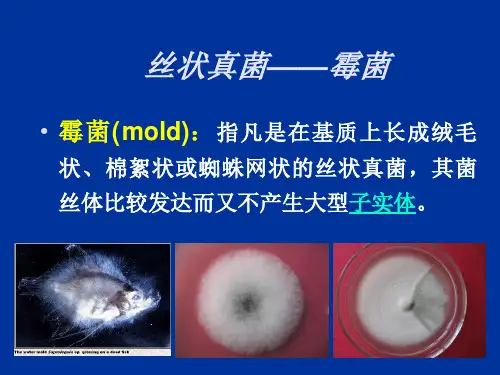

霉菌
- 格式:ppt
- 大小:4.24 MB
- 文档页数:34

霉菌名词解释霉菌,也称为真菌,是一类较为原始的生物,它们与植物和动物有亲缘关系,但却有着明显的区别。
霉菌体形多样,包括单细胞、菌丝体、子实体等形态。
霉菌在自然界中广泛分布,包括水体、土壤、空气、植物、动物等各种环境中都存在着不同种类的霉菌。
霉菌与人类生活息息相关,它们不仅在食品、农作物、草木等方面起到重要的生物降解作用,还是生物技术、药物研发等领域的重要研究对象。
然而,一些霉菌也是人类疾病的致病因子,它们可以产生毒素或侵袭人体组织导致感染和疾病的发生。
霉菌的命名根据其形态、生态、生理特征等方面进行分类,以下是几个常见的霉菌名词解释:1. 黑曲霉(Aspergillus niger):黑曲霉广泛存在于土壤中,喜欢潮湿的环境,并且可以在许多不同的有机物上生长。
它产生一种名为黑曲霉素的有机酸,具有一定的抗菌作用,常被用于食品加工、酿造等工业中。
2. 霉菌感染(Mycosis):霉菌感染是由霉菌引起的一类疾病,常见的有念珠菌病、曲霉病等。
霉菌感染通常发生在免疫力低下的人群中,如接受免疫抑制治疗、器官移植等人群。
3. 霉热病(Allergic bronchopulmonary aspergillosis, ABPA):霉热病是一种由霉菌引起的过敏反应性疾病,以呼吸道为主要累及部位。
常见的症状包括咳嗽、咳痰、呼吸困难等。
4. 真菌性皮肤感染(Cutaneous fungal infection):真菌性皮肤感染是指由各种霉菌引起的皮肤疾病,常见的包括白色念珠菌感染、股癣、脚癣等。
这些感染通常通过接触感染源如土壤、患者、动物等传播。
5. 伞菌目(Agaricales):伞菌目是霉菌门中最大的一个目,包括许多食用蘑菇和毒蘑菇的物种,如:香菇、蘑菇、牛肝菌等。
伞菌目的菌丝体嵌入在地下或树木内,只有子实体在空气中生长。
霉菌在生态系统中发挥重要的功能,它们能够分解和分解大量有机物质,参与环境循环过程,对维持自然平衡起到重要作用。


霉菌的分类霉菌是一类真核生物,它们的细胞结构与动植物相似,但是它们不属于动物或植物。
霉菌在自然界中广泛存在,包括土壤、水体、空气和生物体内等多种环境中。
霉菌具有重要的经济和生态价值,在生产和科研领域中也有着广泛的应用。
一、霉菌的基本特征1.细胞结构霉菌细胞通常由细胞壁、质膜、质网、核膜和线粒体等组成。
其中,细胞壁是霉菌的重要特征之一,它由纤维素和几丁质等多种复合材料构成,具有很强的韧性和耐腐蚀性。
2.营养方式霉菌大多数为异养生物,它们通过吸收周围环境中的有机物质来获取营养。
同时,部分霉菌也能够进行光合作用或化学合成。
3.繁殖方式霉菌繁殖方式多样,包括无性繁殖和有性繁殖两种。
其中无性繁殖包括分裂、芽生和孢子形成等多种方式,而有性繁殖则需要两个不同的细胞进行交配和配子形成。
二、霉菌的分类霉菌是一类非常庞大的生物群体,根据其形态、生理特征、遗传信息等多种因素,可以将其分为多个类群。
以下是常见的霉菌分类:1.按照形态特征分类(1)酵母菌类:这类霉菌体积较小,通常为单细胞结构,具有球状或卵圆形等多种形态。
(2)真菌类:这类霉菌体积较大,通常为多细胞结构,具有丝状或分枝状等多种形态。
(3)粘液菌类:这类霉菌具有一定的动物特征,在营养方式和繁殖方式上也与其他霉菌存在差异。
2.按照生理特征分类(1)厌氧性霉菌:这类霉菌能够在缺氧环境下进行代谢和生长,并且对氧气敏感。
(2)好氧性霉菌:这类霉菌需要充足的氧气来进行代谢和生长,对缺氧环境敏感。
(3)光合作用霉菌:这类霉菌能够利用光能进行自主合成,具有较高的生态适应性。
3.按照遗传信息分类(1)真菌门:这类霉菌具有真核细胞结构和线粒体等多种细胞器,其基因组较为复杂。
(2)原生动物门:这类霉菌具有原核结构和一些特殊的生理特征,其基因组相对简单。
三、常见的霉菌种类1.酵母菌酵母菌是一类常见的单细胞真菌,它们广泛存在于自然界中。
其中最常见的酵母菌是酿酒酵母和面包酵母等。
此外,酵母菌还可以用于发酵、制药、食品加工等多种领域。



霉菌名词解释霉菌是一类微生物,它们是真菌界中的一种。
霉菌是一种单细胞或多细胞的生物,它们通常以孢子的形式存在。
霉菌在自然界中广泛分布,可以生长在土壤、水、植物、动物和人类身上。
霉菌可以分解有机物质,也可以引起疾病。
以下是一些常见的霉菌名词解释:1. 黑曲霉(Aspergillus niger)黑曲霉是一种广泛存在于自然界中的真菌,它们通常生长在植物和土壤中。
黑曲霉可以分解有机物质,也可以用于制作酶和酸。
此外,黑曲霉还被用于制作一些食品和饮料,如黑啤酒和黑曲霉豆腐。
2. 霉菌素(Myco-toxin)霉菌素是一种由霉菌分泌的毒素,它们可以在食品和饲料中被发现。
霉菌素可以引起广泛的健康问题,包括呼吸道感染、肝脏损伤和肾脏损伤。
霉菌素的危害在于它们可以在食品和饲料中积累,因此需要采取措施来避免霉菌素的污染。
3. 霉菌感染(Mycosis)霉菌感染是一种由霉菌引起的疾病,它们通常影响皮肤、毛发和指甲。
霉菌感染可以通过直接接触感染源或在潮湿环境中感染。
霉菌感染的治疗通常包括使用抗真菌药物。
4. 霉菌病(Mycotoxicosis)霉菌病是一种由霉菌素引起的疾病,它们通常通过食品和饲料中的霉菌素污染引起。
霉菌病的症状包括恶心、呕吐、腹泻、头痛和发热。
霉菌病的治疗通常包括使用抗真菌药物和支持性治疗。
5. 霉菌培养基(Mycological media)霉菌培养基是一种用于培养霉菌的营养基质,它们通常包括葡萄糖、酵母提取物和肉汤。
霉菌培养基可以用于分离和鉴定霉菌,以及研究霉菌的生长和代谢。
6. 真菌感染(Fungal infection)真菌感染是一种由真菌引起的疾病,包括霉菌感染和酵母菌感染。
真菌感染通常影响皮肤、呼吸道、消化道和泌尿生殖系统。
真菌感染的治疗通常包括使用抗真菌药物和支持性治疗。
7. 真菌学(Mycology)真菌学是研究真菌的科学,包括霉菌和酵母菌。
真菌学涉及真菌的形态、生长、代谢和分类等方面的研究。


霉菌的名词解释霉菌(Mycetes),也叫真菌(Fungi),是一类单细胞或多细胞的真核生物,属于生物界真菌门。
I. 什么是霉菌?霉菌是一类原生生物体,与植物、动物和细菌构成生物界的四个主要类别之一。
与植物不同,霉菌无法进行光合作用,它们以腐败、寄生或互生的方式从有机物中获取营养。
霉菌是地球上最古老的生物之一,它们在地球上的存在可以追溯到约13亿年前。
II. 霉菌的形态结构霉菌的形态结构包括菌丝、菌落和孢子。
1. 菌丝(Hyphae):霉菌由微细的菌丝组成,它们是无色的、细长的管状结构,有较高的分枝率。
菌丝可以在有机物附近扩散和穿透有机物的内部,以吸收营养。
2. 菌落(Mycelium):菌丝彼此交织在一起形成的结构被称为菌落。
菌落往往与霉菌的外观和颜色有关。
3. 孢子(Spores):霉菌通过产生孢子进行繁殖。
孢子是一种单细胞结构,它们可以被风或其他介质传播到新的环境中。
当孢子找到合适的环境时,它们会发芽成长为新的菌丝,从而形成新的菌落。
III. 霉菌的生活方式霉菌的生活方式分为母细胞分裂和有性繁殖两种。
1. 母细胞分裂:霉菌的菌丝会经历母细胞的分裂,产生两个完全相同的子细胞。
这种方式是霉菌最常见的繁殖方式,也是它们繁衍后代的主要方式。
2. 有性繁殖:在某些情况下,霉菌会进行有性繁殖。
这通常发生在环境条件不适宜时,霉菌会通过与其他相同或不同种类的霉菌交配来产生新的细胞株。
这个过程中,菌丝会结合成一个叫做子实体的结构,其中结合的两个菌丝各提供一部分细胞核,形成一个双核的细胞。
随后,这个双核细胞会发育成为一个新的菌落。
IV. 霉菌的分类和应用霉菌可以根据其生活方式和外观进行分类。
根据其生活环境可以分为土壤霉菌、水霉菌、空气霉菌等。
根据其形态结构可以分为毛霉菌、酵母菌、根霉菌等。
不同类型的霉菌在生活中发挥着重要的作用。
1. 食品加工:霉菌被广泛用于发酵食品的制备过程中,例如酸奶、面包和啤酒等。
它们可以分解有机物质并产生特定的化学物质,改变食品的口味和质地。


霉菌名词解释霉菌是一类在自然界中广泛分布的微生物,它们具有重要的生态和经济意义。
本文将对霉菌的基本特征、分类、生态、代谢、应用等方面进行较为详细的解释。
一、基本特征霉菌是真菌门下的一个类群,它们通常具有以下几个特征:1.菌体多为丝状,由单细胞生长而成。
2.菌体表面常有分枝、瘤状或孢子囊等结构。
3.菌体通常为单细胞或多细胞的有性或无性生殖。
4.菌体能够分泌各种酶类和代谢产物,参与生态系统的物质循环。
二、分类霉菌是一类非常广泛的真菌,包括了许多种类和亚种。
它们的分类方式有多种,主要可分为以下几个层次:1.菌种:霉菌按照形态、生态、代谢等特征分为各种不同的菌种,如链霉菌、青霉菌、曲霉菌等。
2.属:多个菌种可以归为同一属,如青霉属、曲霉属、放线菌属等。
3.科:同一属的霉菌可以归为同一科,如青霉科、曲霉科、放线菌科等。
4.门:同一科的霉菌可以归为同一门,如真菌门、放线菌门等。
三、生态霉菌广泛分布于自然界中的各种环境中,如土壤、水体、空气、植物、动物等。
它们可以利用各种有机物质为营养来源,参与生态系统的物质循环。
霉菌在生态系统中的作用非常重要。
它们能够分泌各种酶类,如纤维素酶、淀粉酶、蛋白酶等,分解各种有机物质,促进有机物的循环。
此外,霉菌还能够与其他生物形成互惠共生关系,如与植物根系共生、与昆虫共生等。
四、代谢霉菌具有多样化的代谢途径和代谢产物。
它们可以利用各种有机物质为营养来源,同时还能够分泌各种代谢产物,如抗生素、酶类、有机酸等。
其中,霉菌分泌的抗生素具有非常重要的医学和农业意义。
抗生素可以用于治疗各种细菌感染病,如肺炎、脑膜炎、结核病等。
此外,抗生素还可以用于农业生产中的动植物疾病防治。
五、应用霉菌在医学、农业、食品等领域中具有广泛的应用价值。
以下列举几个典型的应用:1.药物制造:霉菌分泌的抗生素可以用于治疗各种细菌感染病,如链霉素、青霉素、四环素等。
2.食品加工:霉菌可以用于食品的发酵、腌制、熟化等过程,如豆腐、酱油、奶酪等。
霉菌ppt课件完整版contents •霉菌概述•霉菌形态与结构•霉菌生理生化特性•霉菌在自然界中的作用•霉菌与人类的关系•实验诊断与检测技术目录定义与分类定义霉菌是一类真菌,属于真菌界中的一大类生物,包括许多对人类有益的物种,也有一些能引起人类和动植物疾病的物种。
分类根据形态和生态特征,霉菌可分为多个类群,如毛霉、根霉、曲霉、青霉等。
霉菌主要通过分解和吸收有机物来获取营养,属于异养生物。
营养方式繁殖方式生长条件霉菌主要通过无性繁殖(如孢子繁殖)和有性繁殖(如接合生殖)进行繁殖。
霉菌生长需要适宜的温度、湿度和pH 值等条件,不同种类的霉菌对这些条件的要求有所不同。
030201生物学特性生态环境与分布生态环境霉菌广泛分布于自然界中,包括土壤、水体、空气以及各种动植物体表和体内。
与人类的关系霉菌与人类关系密切,一方面可以为人类提供食品、药品和工业原料等;另一方面也可能引起食品霉变、动植物疾病和人类疾病等问题。
分布特点霉菌的分布具有广泛性、多样性和地域性等特点,不同地区的霉菌种类和数量可能存在差异。
伸入培养基内吸收养分的菌丝,无色或有色,直径比气生菌丝细。
营养菌丝营养菌丝向空中生长的菌丝,又称二级菌丝。
气生菌丝气生菌丝发育到一定阶段,成为紧密排列的直线菌丝,又称三级菌丝。
直立菌丝菌丝体形态孢子形态与结构无性孢子由菌丝体直接产生的孢子,如节孢子、厚垣孢子、分生孢子等。
有性孢子通过两个性细胞或菌丝结合后形成的孢子,如接合孢子、卵孢子、子囊孢子、担孢子等。
菌索由菌丝体平行排列而成的绳索状结构,有些霉菌的菌索内可形成厚垣孢子或分生孢子。
菌核由菌丝紧密交织而成的休眠体,内层是疏丝组织,外层是拟薄壁组织,表皮细胞壁厚、色深、较坚硬。
吸器某些寄生性霉菌在菌丝上形成的特殊器官,用以伸入寄主细胞内吸收养分。
特殊结构碳源氮源矿物质和维生素代谢途径营养需求与代谢途径霉菌能利用多种碳源,如葡萄糖、果糖、麦芽糖等单糖和双糖,也能利用淀粉、纤维素等多糖。
霉菌知识点总结霉菌在生物圈中扮演着非常重要的角色,它们参与了地球上几乎所有生物系统的运行和平衡,其中一些霉菌还具有极高的价值,被应用在食品加工、药物生产等多个领域。
不过,霉菌同时也是一类致病微生物,对于人类和动植物来说,有些霉菌会引发一系列健康问题。
以下是一些关于霉菌的基本知识点总结:1. 霉菌的结构和生活方式霉菌的主要形态是菌丝体,也就是由细胞组成的细长的丝状结构,这是霉菌的一种基本形态。
霉菌的生存和繁殖主要通过分离芽孢的方式进行。
一般情况下,霉菌在适宜的环境和条件下,通过分裂繁殖。
分裂实际上是指活细胞内的细胞核先分裂再由此使细胞质分裂,并在适宜的环境和条件下逐渐成长。
2. 霉菌的生长环境霉菌是一类极易生长的微生物,它们通常以天然的有机物为食,例如纤维、纸张、食品、皮革:而寄生在动植物体表的霉菌则可以在它们的表面或内部生长。
霉菌的生长需要湿度、温度和氧气,只有在适宜的湿度和温度条件下,霉菌才能生长和繁殖。
3. 霉菌与人类健康霉菌也可以对人类的健康造成一定危害。
例如,某些霉菌产生的毒素,比如黄曲霉毒素和赤霉素,可以通过食物和空气对人造成严重的危害。
实际上,霉菌对人类引发的疾病有各种各样的形式,例如过敏,感染(呼吸系统,皮肤),和真菌病。
4. 霉菌的应用和价值尽管霉菌会引发健康问题,但同时也有一些霉菌在食品、医药和科学等领域中具有非常重要的应用价值。
例如,在食品行业中,霉菌可以发酵生产酒精、豆瓣酱等食品;在医药行业中,霉菌产生的青霉素和链霉素等抗生素对于治疗一些细菌感染症状具有重要作用。
5. 霉菌的防治维持生活周边环境的卫生,降低栽培、储存、加工时禾谷等粮食和副食品含水量和含水保持活性的可能性;抑制霉菌生物修复、保健、令人舒适、减少细胞膜的损伤等,我们要想合理使用这些方法。
总结来说,霉菌是一类常见的微生物,它们在自然界中扮演着非常重要的角色。
虽然一些霉菌对于人类健康造成危害,但是另外还有一些霉菌具有重要的应用价值。
霉菌医学名词解释
霉菌是一类真菌的通称,也叫做霉菌门或子囊菌门。
霉菌广泛存在于自然界中,包括土壤、空气、食物等环境中。
它们通常是以菌丝的形式存在,能够对有机物进行分解并吸收养分。
有些霉菌是有益的,如用于食品加工、制药和生物工程等领域,但也有一些霉菌对人类和动物造成健康问题。
以下是几个与霉菌相关的医学名词解释:
1. 霉菌感染:霉菌感染是指人体受到霉菌感染引起的疾病。
常见的霉菌感染包括念珠菌感染、曲霉菌感染等。
这些感染通常发生在免疫功能低下的人群中,如艾滋病患者、免疫抑制剂使用者等。
2. 霉菌病:霉菌病是指由霉菌引起的疾病的总称。
不同的霉菌可以引起不同的疾病,如肺型曲霉菌病、皮肤念珠菌病等。
3. 霉菌毒素:霉菌产生的一种化合物,具有毒性作用。
霉菌毒素广泛存在于食物中,如黄曲霉素、赭曲霉素等。
长期摄入霉菌毒素可能对健康产生负面影响,如肝脏损害、免疫系统抑制等。
4. 霉菌致敏:霉菌产生的过敏原物质引起人体过敏反应。
霉菌致敏常见于湿度高、通风差的环境中,可导致过敏性鼻炎、哮喘等疾病。
总之,霉菌是一类真菌,与人类健康密切相关,可以引起感染、疾病和过敏等问题。
霉菌的形态结构霉菌是一类单细胞真菌,其形态结构多样且复杂,包括菌丝、分生孢子、子实体等。
1. 菌丝:菌丝是霉菌最常见的形态结构,通常呈无色或白色。
菌丝由一个个细长而细胞不等长的细胞组成,细胞之间通过细胞壁相连形成一个个链状结构。
菌丝能够在基质上延伸生长,从而形成一个网状的菌丝体。
2. 分生孢子:霉菌的分生孢子是繁殖的主要方式之一。
它们通常呈圆形、椭圆形或长圆柱形,具有细胞壁,可以单独存在或聚集在一起。
分生孢子可以通过风、水、动物等方式传播,从而在不同的环境中繁殖。
3. 子实体:子实体是霉菌生命周期中的一个重要阶段。
它们通常是由菌丝聚集而成,呈现出不同的形态和颜色。
子实体内部含有大量的分生孢子,当环境适宜时,子实体会释放出分生孢子,从而完成繁殖过程。
4. 菌核:菌核是一种特殊的结构,常见于一些霉菌中。
菌核通常是由菌丝聚集而成,呈现出颗粒状或球状。
菌核内部含有大量的分生孢子,可以在适宜的环境下迅速发芽,形成新的菌丝体。
5. 顶端生长:霉菌的菌丝通常是从顶端生长的,也就是从菌丝的末端不断延伸,形成新的菌丝。
这种顶端生长方式使得霉菌能够适应不同的环境并寻找到更多的营养物质。
6. 侧面分枝:除了顶端生长,霉菌的菌丝还可以通过侧面分枝的方式增加菌丝的数量和长度。
侧面分枝通常发生在菌丝的侧面,使得菌丝的形态更加复杂多样。
7. 菌丝的交织:不同的霉菌菌丝可以在一起交织形成复杂的菌丝体。
这种交织使得菌丝体更加牢固,并且可以在基质上形成广泛的网络结构。
8. 菌丝的颜色:不同的霉菌菌丝具有不同的颜色,可以是白色、灰色、褐色、黑色等。
这种颜色的差异通常是由于菌丝内部或外部的色素物质所致。
9. 菌丝的粘附:菌丝通常具有一定的粘附性,可以黏附在不同的基质上。
这种粘附性使得霉菌能够在不同的环境中生长并获取营养。
10. 菌丝的分裂:霉菌的菌丝可以通过分裂的方式进行繁殖。
在适宜的条件下,菌丝会发生分裂,形成新的菌丝体。
总结起来,霉菌的形态结构包括菌丝、分生孢子、子实体等,这些结构使得霉菌能够适应不同的环境并完成繁殖过程。
霉菌是真菌的一种,其特点是菌丝体较发达,无较大的子实体。
霉菌的基本特征包括形态、菌落构造和繁殖方式等方面。
1.形态:霉菌的形态多样,其菌丝通常较粗而长,菌落较大,质
地疏松,外观干燥,不透明,常呈现或松或紧的形状。
此外,
霉菌菌落与培养基间的连接紧密,不易挑取,其正反面的颜色、
构造,以及边缘与中心的颜色、构造常不一致。
2.菌落构造:霉菌的菌丝有营养菌丝和气生菌丝的分化,而气生
菌丝没有毛细管水,因此它们的菌落与细菌或酵母菌的不同,
而与放线菌相似。
3.繁殖方式:霉菌主要通过孢子进行繁殖,其孢子形态各异,如
大型复杂纤维状孢子菌、枝状孢子体、单芽孢子体等。
这些孢
子可以通过空气传播,使得霉菌的分布广泛。
除此之外,霉菌的生长条件要求较低,在湿度为85%~90%以上、温度为25℃~30℃的环境中能迅速生长繁殖。
霉菌的细胞壁主要成分为几丁质,这使得它们对环境的适应性较强。
然而,霉菌对人体健康可能产生危害,如慢性中毒、致癌、致畸、致突变作用等。
这主要源于霉菌产生的有毒代谢产物,如黄曲霉毒素等。
因此,在日常生活中,我们需要注意防霉、除霉,保持环境的干燥和清洁,以减少霉菌的滋生和传播。